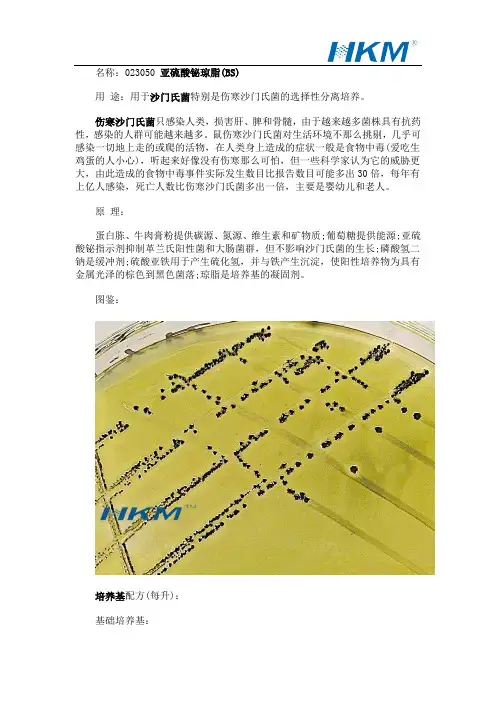

沙门氏菌操作记录(质控)
- 格式:doc
- 大小:57.00 KB
- 文档页数:4

食品微生物学检验 沙门氏菌检验GB GB 4789.44789.44789.4-20-20-201010北京陆桥技术有限责任北京陆桥技术有限责任公司公司技术服务电话:010-******** 销售服务电话:010-********技术部邮箱:luqiaotech@www. beijinglandbridge .com北京陆桥技术有限责任公司目 录�沙门氏菌简介�2010版国标主要修订内容�沙门氏菌的检验步骤及注意事项�沙门氏菌检验过程中的常见问题www. beijinglandbridge .com 北京陆桥技术有限责任公司沙门氏菌简介�沙门氏菌属沙门氏菌属:肠杆菌科:肠杆菌科�沙门氏菌能引起胃肠炎、伤寒、败血症等人类疾病,严重时能导致死亡。
�种类繁多,抗原结构复杂,种类繁多,抗原结构复杂,在在《ANTIGENIC FORMULAE OF THE SALMONELLA SEROVARS FORMULAE OF THE SALMONELLA SEROVARS》》(2007 9th edition)(2007 9th edition)中已公布了中已公布了2579个血清型个血清型。
�食物是人类感染沙门氏菌的主要途径。
www. beijinglandbridge .com 北京陆桥技术有限责任公司�形态特征:形态特征:革兰氏阴性革兰氏阴性革兰氏阴性、、两端钝圆短杆菌两端钝圆短杆菌,,无芽孢无芽孢,,一般无荚膜,除鸡沙门氏菌一般无荚膜,除鸡沙门氏菌和和雏沙门氏菌外,都有周身鞭毛,运动力强�培养特性:需氧或兼性厌氧,10℃~42℃都可生长,最适生长温度为37℃,最适pH 为6.8~7.8�革兰氏阴性、需氧或兼性厌氧无芽孢杆菌沙门氏菌简介:生物学特征www. beijinglandbridge .com 北京陆桥技术有限责任公司�修改了标准的中英文名称�修改了标准的范围�修改了培养基和试剂;�修改了设备和材料;�修改了附录修改了附录A A (规范性附录)培养基和试剂2010版国标主要修订内容www. beijinglandbridge .com 北京陆桥技术有限责任公司——关于培养基和试剂的修订说明�修改了修改了HE HE HE琼脂和三糖铁琼脂的配方。

检测沙门氏菌的注意事项沙门氏菌是一种革兰氏阴性杆菌,常引起人和动物的食物中毒。
如何正确地进行沙门氏菌的检测非常关键,下面是一些注意事项:1.实验室条件:执行沙门氏菌的检测需要一个干净、整洁、无菌的实验室环境。
实验室应具备适当的设备,如培养箱、显微镜、离心机等,并保持适宜的温度和湿度。
2.培养基的选择:沙门氏菌的生长需要适宜的培养基。
常用的培养基包括牛肉提取物琼脂(B G A)、X L D琼脂、S S琼脂等。
在选择培养基时,应根据需要检测的样品类型和具体实验要求进行选择。
3.样品处理:在进行沙门氏菌检测前,需要对样品进行适当的处理。
不同样品的处理方法有所不同,如食品样品通常需要经过样品预处理、富集培养和菌落鉴定等步骤。
要注意避免交叉污染,使用无菌操作器具,避免使用过期的培养基和试剂。
4.培养条件:沙门氏菌的最适温度为37℃,在此温度下生长最佳。
因此,在进行培养时需要控制适宜的温度。
同时,还需要提供适当的氧气条件,如使用倾斜培养法,避免菌落重叠。
5.鉴定方法:沙门氏菌的鉴定通常包括生理生化试验和分子检测方法。
常用的生理生化试验如糖发酵试验、产气试验、硫代硫酸盐试验等。
分子检测方法如聚合酶链式反应(P C R)、荧光原位杂交(F I S H)等。
为了提高准确性和可靠性,建议在实验过程中使用多种方法进行鉴定。
6.质量控制:为了保证检测结果的准确性,需要进行质量控制。
质控样品可以是已确认为阳性或阴性的样品,用于验证检测方法的灵敏度和特异性。
同时,在实验过程中还需要进行一些质量控制措施,如检测前对培养基进行无菌性验证,对实验操作进行记录和审核等。
7.数据分析和解读:在完成实验后,需要对结果进行适当的数据分析和解读。
对于阳性结果,应注意区分真阳性和假阳性。
可以使用统计学方法对阳性结果进行分析,评估其显著性和可靠性。
总之,正确进行沙门氏菌的检测非常重要,需要注意实验室条件、培养基的选择、样品处理、培养条件、鉴定方法、质量控制以及数据分析和解读等方面。


第 页,共 页沙门氏菌检验原始记录表检测员: 校核人: 审核人:年 月 日 年 月 日 年 月 日样品编号检测类别环境条件温度: ℃ 湿度: %检测标准 医疗水污染物排放标准 医疗机构污水和污泥中沙门氏菌的检验方法 GB18466-2005 附录B设备名称设备编号增菌□ 污水 移取200mL 污水,用灭菌滤膜抽滤,用100mL 二倍浓度SF 增菌液将滤膜上的杂质洗脱到灭菌三角烧瓶中,摇匀。
37℃下培养12~24h□ 污泥 称取20g 污泥,加200mL 灭菌水,制成1:10混悬液,移取100mL 混悬液,加入到装有100mL 二倍浓度SF 增菌液的已灭菌三角烧瓶中,摇匀。
37℃下培养24h检验项目现象初判断分离 培养SS 培养基平板 37℃培养, h (24~48h )BS 培养基平板 37℃培养, h (24~48h )生化试验表1 在TSI 试验培养基内的反应结果TSI 培养基 37℃培养, h (18~24h )初步判断斜面 底层 产气 硫化氢注:K :产碱,A :产酸;+:阳性,—阴性:初步判断:可疑沙门氏菌或非沙门氏菌。
表2 生化反应初步鉴定表葡萄糖甘露醇 麦芽糖乳糖 蔗糖 靛基质 硫化氢 动力 尿素酶注:+阳性;-阴性;+/-阳性或阴性表3 补做试验(选做)侧金盏花醇水杨素 氰化钾结果判断注:+:阳性,-:阴性;结果判断:沙门氏菌或非沙门氏菌。
血清学鉴定盐水 ,多价抗O 型抗血清( A-F ) 。
结果 mL 样品中 沙门氏菌 备注。

德州市德城区疾病预防控制中心
检测原始记录之一
共页第页检品编号物态/颜色
检测项目沙门氏菌检验检测依据GB 4789.4-2010 食品微生物学检验沙门氏菌检验
设备名称隔水式电热恒温培养箱设备编号
1 检验方法:
1.1 前增菌:加225mL BPW增菌液均质混匀,℃培养小时,日时至日时。
1.2 增菌:轻轻摇动培养物,取1mL接种于10 mL TTB内,℃培养小时,日时至日时。
同时另取1mL接种于10mL SC内,℃培养小时,日时至日时。
1.3 分离:分别用接种环取增菌液1环划线接种BS琼脂平板一个,℃培养小时,日时至日时。
同时另取增菌液1环划线接种沙门氏菌显色培养基平板一个,℃培养小时,日时至日时。
观察菌落生长状况:可疑菌落生长。
1.4 初步生化:若有可疑菌落生长,挑取各选择性平板上2个以上典型或可疑菌落,接种三糖铁琼脂,赖氨酸脱羧酶试验培养基和营养琼脂平板,于℃培养小时,日时至日时,也可同时接种蛋白胨水(供作靛基质试验)、尿素琼脂(pH7.2)、氰化钾(KCN),于℃培养小时,日时至日时,必要时进行系统生化鉴定及血清学凝集。
初步生化结果:
葡萄糖乳糖蔗糖H2S 产气动力靛基质pH7.2尿素氰化钾赖氨酸脱羧酶
1.5系统生化鉴定:API 20E 生化条:
1.6 血清学凝集:
2 检验结果:根据GB 4789.4-2010食品微生物学检验沙门氏菌检验,在中沙门氏菌。
检测起止时间:年月日时至年月日时
检测人:审核人:
检测原始记录、检测报告存根、检测申请及受理单等合并归档保存。
DCQJY/JLBG 127。




1.适用范围适用于沙门氏菌属的检验。
2.引用标准SN0170-92 食品卫生微生物学检验3.设备和材料温箱:36 ± 1 ︒C 42±1℃灭菌吸管:1ml 10ml 灭菌试管:12*100mm灭菌平皿电子天平酒精灯玻璃棒金属匙接种环接种针广口瓶:250ml 500ml 锥形瓶:100ml 500ml4.培养基和试剂的制作:(A) 缓冲蛋白胨水(BPW)准确称取4.5g(±0.1g)BPW,倒入500ml锥形瓶中并加入225ml蒸馏水搅拌均匀,静置约10min,加热煮沸至完全溶解后注入500ml的广口瓶中,高压灭菌121℃、15min冷却后储存冰箱备用。
(B)亚硒酸盐胱氨酸增菌液(SC)准确称取2.3g(±0.1g)SC,倒入250ml锥形瓶中加入100ml蒸馏水搅拌均匀静置约10min完全溶解后,注入250ml的广口瓶中储存冰箱备用。
(稍加热可加快溶解速度)(C)硫酸铋琼脂(BS)准确称取4.96g(±0.1g)BS,倒入250ml锥形瓶中并加入100ml蒸馏水浸泡15min后,加热煮沸至完全溶解冷却至50-60℃,迅速倾注5-8个灭菌平皿中储存冰箱内备用。
(D) 胆硫乳琼脂(DHL)准确称取6.43g(±0.1g)DHL ,倒入250ml 锥形瓶中并加入100ml 蒸馏水搅拌均匀,静置10min, 加热煮沸至完全溶解冷却至50-60℃, 迅速倾注5-8个灭菌平皿中储存冰箱 内备用。
(本培养基以当天配制,第二天使用为佳) (E) 三糖铁琼脂(TSI准确称取6.5g(±0.1g)TSI,倒入250ml 锥形瓶中加入100ml 蒸馏水浸泡15min,加热煮沸至完全溶解后分装于试管(12*100mm),每管约装2-4ml 高压灭菌115℃,15min 灭菌后置成高层斜面冷却后储存冰箱备用。
5. 沙门氏菌的检验程序如下:36±1℃ 24±2h6.操作步骤1)前增菌:准确称取25 g(±1g)检样(剪碎),加入225 ml缓冲蛋白胨水,混匀制成混悬液置于36±1℃温箱中培养24±2h。

沙门氏菌检验国家标准沙门氏菌是一种常见的致病菌,可以通过食物、水源和接触感染等途径传播,引起食物中毒和肠道感染等疾病。
为了保障食品安全和公共卫生,我国对沙门氏菌的检验标准进行了规范,制定了相应的国家标准。
首先,沙门氏菌检验国家标准明确了检验对象和范围。
该标准适用于食品、饮用水、环境样品等的沙门氏菌检验,包括沙门氏菌的定性和定量检验方法。
针对不同的检验对象,标准中规定了具体的检验方法和技术要求,确保检验结果的准确性和可靠性。
其次,标准对沙门氏菌的检验方法进行了详细的描述。
在样品的处理和预处理过程中,标准规定了严格的操作要求,包括样品的采集、保存、运输和处理等。
针对不同的样品类型,标准中还规定了不同的处理方法,以确保样品中沙门氏菌的检出率和准确性。
此外,标准还对沙门氏菌的培养和鉴定方法进行了规范。
在培养基的选择和制备过程中,标准明确了培养基的成分和制备方法,以及培养条件和培养时间等。
在沙门氏菌的鉴定过程中,标准规定了生化试剂的选择和使用方法,以及鉴定结果的判定标准,确保鉴定结果的准确性和可靠性。
最后,标准对沙门氏菌的定量检验方法进行了规定。
在定量检验过程中,标准规定了菌落计数方法和计数结果的表达方式,以及检验结果的判定标准。
同时,标准还规定了质控要求和质控方法,确保检验结果的可比性和可靠性。
总的来说,沙门氏菌检验国家标准的制定为我国食品安全和公共卫生提供了重要的技术支撑和保障。
通过严格执行该标准,可以有效地预防和控制沙门氏菌引起的食物中毒和肠道感染等疾病,保障人民群众的身体健康和生命安全。
希望各相关部门和单位能够认真贯彻执行该标准,不断提升沙门氏菌检验工作的水平和质量,为我国食品安全和公共卫生事业作出积极贡献。
________疾病预防控制中心沙门氏菌检验原始记录共 页 第 页检验者: 审核者: 年 月 日样品编号样品名称检验依据 GB 4789.4-2010检验环境温度 ℃ 湿度 %RH检验日期仪器设备名称、规格型号、精度、编号电子天平: YP-1002 0.01g 105 有计量合格标识,并在检定有效期内. 恒温培养箱: DH6000 0.1℃ 88 有计量合格标识,并在检定有效期内.样品复苏 __月__日_____ 无菌操作,将待检样品磁珠置于10mL 无菌营养肉汤中37℃温育24h 复苏。
前增菌 __月__日_____按无菌操作取待检肉汤1mL ,加入到10 mL BPW 增菌液中,充分混匀,于36±1℃培养4h 。
增菌__月__日_____取1mLBPW 增菌液,转种于10mLSC 增菌液中,于36±1℃培养18~24h 。
检验项目现象结果 分离 培养BS 琼脂平板要求 36±1℃,40h-48h培养 ___日____时至__日____时。
HE 琼脂 平板 要求 36±1℃,18h-24h 培养 ___日____时至__日____时。
____显色平板 要求 36±1℃,18h-24h培养___日____ 时至__日___时。
生化 试验三糖铁琼脂要求 36±1℃,18h-24h 培养 ___日____时至__日____时。
普通琼脂平板 要求 36±1℃,18h-24h 培养 ___日____时至___日____时。
赖氨酸脱羧酶试验 API20E 生化试剂盒 要求 36±1℃,18h-24h 编码 结果 培养___日___时至___日___时。
血清学鉴定实验结果 样品中 沙门氏菌备注。
实验室沙门氏菌检验能力验证结果与分析作者:殷欢来源:《现代食品》 2019年第2期沙门氏菌广泛分布在自然界中,是能够导致人畜共患病的食源性致病菌,易通过人畜传播疾病,易造成水源、食品等的污染,并且能够在短时间内大量繁殖。
伤寒、急性肠胃炎、菌血症和败血症等疾病皆是由沙门氏菌感染所引起的。
严重致死病例多见于老人、幼童及免疫系统有缺陷的易感人群[1]。
在沙门氏菌的检验中,生化鉴定存在一定的难度,传统的食品安全国家标准中生化鉴定需要操作者有较好的工做经验。
因此实验室的食品微生物检验能力直接影响沙门氏菌的检出率,提高检验能力势在必行。
能力验证能够评定实验室从事特定检测或测量的能力,识别实验室存在的问题并启动改进措施,提高实验室的检验能力等[2]。
因此本实验室积极参加能力验证活动,以期积累经验,提高本实验室的沙门氏菌检验能力。
1材料与方法1.1材料待测样品巧克力,批号为NIFDC-PT-135,共3瓶,编号为0853、0149、0156,规格为10 g/瓶。
由中国食品药品检定研究院提供。
1.2培养基及试剂营养琼脂培养基(NA)、缓冲蛋白胨水(BPW)、四硫酸钠煌绿(TTB)增菌液、亚硒酸盐胱氨酸(SC)增菌液、亚硫酸铋(BS)琼脂、木糖赖氨酸脱氧胆盐(XLD)琼脂、三糖铁(TSI)琼脂以及赖氨酸脱羧酶试验培养基均购自北京陆桥技术有限责任公司。
沙门氏菌显色培养基(CAS)由科玛嘉公司生产。
SX2增菌液、革兰氏阴性细菌鉴定卡GN卡、API20E试剂盒、VIDAS沙门氏菌属筛检试剂条(SLM)由法国生物梅里埃公司提供。
全自动微生物基因指纹鉴定系统(RiboPrinter)配套试剂由美国杜邦公司提供。
1.3实验仪器法国生物梅里埃公司生产的全自动免疫检测系统(MINI VIDAS),全自动微生物生化鉴定系统(VITEK2Compact);美国杜邦公司生产的Ribo Printer全自动微生物基因指纹鉴定系统;美国BAKER公司生产的SG603A-HE型生物安全柜;德国宾得公司生产的BD260型电热恒温培养箱;日本Hirayama公司生产的HVA-85型高压灭菌器等。
五、结果分析条件设定:使用Roche 荧光PCR检测仪1、选择F1或F1/F2通道(建议选择F1/F2通道),点击Quantification 进入定量分析窗口。
2、在Quantification 窗口中,设定Analysis 方式为Fit points , Adjustment 方式为proportional;选定Noise band 项,阈值(Noise band cursor)设定以刚超过正常阴性对照品扩增曲线(无规则的噪音线)的最高点,且Ct 值不出现任何数值为准,也可根据仪器的实际情况进行调整。
使用ABI系列荧光PCR 检测仪进行结果分析时基线(baseline)的确定:取3—10 或3—15 个循环的荧光信号。
阈值(threshold)设定原则以阈值线刚好超过正常阴性对照品扩增曲线(无规则的噪音线)的最高点,且不出现Ct值为准。
使用博日Line-Gene荧光PCR检测仪时,在运行扩增程序前,先把增益值调至30左右。
运行结束后点击数据分析进入结果分析界面,选择样点拟合法进行结果分析:零点调整取1-10 或1-15 个循环的荧光信号;在噪声容限界面下调整基线位置,其设定原则以阈值线刚好超过正常阴性对照扩增曲线(无规则的噪音线)的最高点为准,选择定量分析,对样本进行结果分析。
使用MJ Opticon 系列荧光PCR检测仪进行结果分析时,先扣除本底信号后再输入1-10或1-15之间的荧光密度值来手动设置ct值或拖动Ct线到合适的位置来确定ct值。
质控标准本试剂盒的灵敏度为:500 copies /ml。
定量检测线性范围为:10-1010 copies/ml。
阴性对照应该没有Ct值显示或显示Ct值为40;阳性对照的Ct值应小于等于30.0,否则实验视为无效。
六、结果判断:1. 检测样本Ct值小于等于35.0时,测定结果有效,可直接报告样本阳性;2. 检测样本Ct值大于35.0且小于40时,重复一次,如果Ct值仍小于40,且曲线有明显的对数增长期,可报告样本阳性,否则报告样本阴性。
沙门菌监测标本采集及检测的基本要点doc————————————————————————————————作者:————————————————————————————————日期:附件2:沙门菌监测标本采集及检测的基本要点一、标本采集标本采集应在2小时内用无菌方法采集新鲜标本,置于灭菌容器中或直接接种于增菌培养基中,写上标本编号并填写采样登记表,将标本与采样登记表一同送到指定实验室,如路途较远,标本要存放在专用的标本运送箱内,包扎好以免容器破损。
1.粪便标本宜在服用抗菌素前采集,尽快送检。
(1)留便用棉拭子采取自然排出的新鲜粪便2~3克。
(2)肛拭用棉拭子在生理盐水中蘸湿后(棉拭子贴管壁挤出多余的液体),轻轻旋转插入肛门内约4~5cm(婴幼儿约2~3cm)处,于紧靠肛环边的隐窝处旋转采集直肠表面黏液后退出,棉拭上要沾有粪便。
采集的粪便标本立即放置采样管送检,如2小时内不能送检时,将肛拭或用采样拭子沾满粪便插入运送培养基(Cary-Blair,C-B)内保存,常温条件下运送至实验室。
2.可疑食品标本固体食品需剪碎和研磨,奶和奶制品可直接取样增菌。
二、标本增菌1.粪便标本将标本立即接种于加有磺胺抑菌剂-亚硒酸盐煌绿的增菌液(Selenite Brilliant Green Sulfa Enrichment,SBG),37℃培养18~24h。
哨点医院可先将标本插入3~5ml缓冲蛋白胨水(Buffered Peptone Water,BPW)中37℃预增菌4~6h,然后再将预增菌处理后的标本按检验项目要求取0.1ml接种至9ml各相应选择性增菌液37℃培养16~18h。
2.食品标本可疑食品固体25g研磨后或液体25ml先于225ml BPW中37℃8~12小时进行前增菌。
取前增菌液0.1ml加入9ml RVS中,置40℃继续增菌16~18小时(此项仅用于暴发食物中毒原因调查时)。
具体操作及所用的培养基、鉴定方法参考《中华人民共和国国家标准(食品卫生微生物学检验沙门氏菌检验)GB 4789.4-2010》。
食品中沙门氏菌检验操作规范1 检验依据本方法参照GB4789.4-2010《食品安全国家标准食品微生物学检验沙门氏菌检验》。
2 设备和材料除微生物实验室常规灭菌及培养设备外,其他设备和材料如下:2.1 冰箱:2 ℃~5 ℃。
2.2 恒温培养箱:36 ℃±1 ℃,42 ℃±1 ℃。
2.3 均质器。
2.4 振荡器。
2.5 电子天平:感量0.1 g。
2.6 无菌锥形瓶:容量500 mL,250 mL。
2.7 无菌吸管:1 mL(具0.01 mL 刻度)、10 mL(具0.1 mL 刻度)或微量移液器及吸头。
2.8 无菌培养皿:直径90 mm。
2.9 无菌试管:3 mm×50 mm、10 mm×75 mm。
2.10 无菌毛细管。
2.11 pH 计或pH 比色管或精密pH 试纸。
2.12 全自动微生物生化鉴定系统。
3 培养基和试剂(按说明书配置或灭菌)3.1 缓冲蛋白胨水(BPW);3.2 四硫磺酸钠煌绿(TTB)增菌液;3.3 亚硒酸盐胱氨酸(SC)增菌液;3.4 亚硫酸铋(BS)琼脂;3.5 HE 琼脂;3.6 木糖赖氨酸脱氧胆盐(XLD)琼脂;3.7 沙门氏菌属显色培养基;3.8 三糖铁(TSI)琼脂;3.9 蛋白胨水、靛基质试剂;3.10 尿素琼脂(pH 7.2);3.11 氰化钾(KCN)培养基;3.12 赖氨酸脱羧酶试验培养基;3.13 糖发酵管;3.14 邻硝基酚β-D 半乳糖苷(ONPG)培养基;3.15 半固体琼脂;3.16 丙二酸钠培养基;3.17 沙门氏菌O 和H 诊断血清;3.18 生化鉴定试剂盒。
4 检验程序沙门氏菌检验程序见图1。
图1 沙门氏菌检验程序5 操作步骤5.1 前增菌称取25 g(mL)样品放入盛有225 mL BPW 的无菌均质杯中,以8 000 r/min~10 000 r/min 均质1 min~2 min,或置于盛有225 mL BPW 的无菌均质袋中,用拍击式均质器拍打1 min~2 min。
XXX中心
沙门氏菌鉴定原始记录
报告单号:共页第页样品名称: 样品数量:
生产厂家:样品性状及包装:
样品来源:检测地点:
采或送样单位:采或送样人:
检验依据:编号或批号:
收样日期:检验日期:
检验项目:分离鉴定致病菌
一、危险性评估:
二、样品前处理
共页第页
血清学凝集试验:
菌种处理:
终末消毒:
四、使用设备、标准菌株和主要试剂:
1、使用设备
恒温培养箱:
恒温培养箱:
显微镜:
高压蒸汽灭菌器:
生物安全柜:
2、标准菌种来源、菌号及代数
沙门氏菌标准菌株:
3、主要试剂、批号及配制记录
SC增菌液:
TTB增菌液:
BS琼脂平板:
科玛嘉沙门氏显色培养基:
三糖铁琼脂:
沙门氏菌诊断血清:
生化鉴定管:
五、检验结果
检毕时间年月日检测者:复核者:
XXX中心
沙门氏菌鉴定原始记录
报告单号:共页第页样品名称: 样品数量:
样品性状及包装:检测地点:
收样日期:检验日期:
检验依据: GB4789.4-2010
检验项目:分离鉴定沙门氏菌
一、样品前处理
用0.45um滤膜过滤500ml水样,将滤膜无菌手续剪碎,分别取适量滤膜进行如下操作。
共页第页
血清学凝集试验:
盐水对照:
沙门氏菌A-F多价O血清:
O4:
O5:
H多价2:
Hf:
三、检验结果
检毕时间年月日检测者:复核者:。